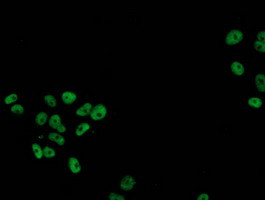
p53 Antibody in Immunocytochemistry (ICC/IF)

Search
OriGene
p53 Monoclonal Antibody (OTI3A6), TrueMAB™
{{$productOrderCtrl.translations['antibody.pdp.commerceCard.promotion.promotions']}}
{{$productOrderCtrl.translations['antibody.pdp.commerceCard.promotion.viewpromo']}}
{{$productOrderCtrl.translations['antibody.pdp.commerceCard.promotion.promocode']}}: {{promo.promoCode}} {{promo.promoTitle}} {{promo.promoDescription}}. {{$productOrderCtrl.translations['antibody.pdp.commerceCard.promotion.learnmore']}}
产品信息
CF502924
种属反应
宿主/亚型
分类
类型
克隆号
抗原
偶联物
形式
浓度
纯化类型
保存液
内含物
保存条件
运输条件
产品详细信息
For reconstitution, we recommend adding 100 µL distilled water to a final antibody concentration of about 1 mg/mL. To use this carrier-free antibody for conjugation experiments, we strongly recommend performing another round of desalting. (Zeba Spin Desalting Columns, 7KMWCO, 0.5 mL, Product # 89882)
靶标信息
The tumor suppressor protein, p53, is a sequence specific transcription factor that is activated by cellular stress. p53 mediates cell cycle arrest or apoptosis in response to DNA damage or starvation for pyrimidine nucleotides. p53 is up-regulated in response to stress signals and stimulated to activate transcription of specific genes, resulting in expression of p21waf1 and other proteins involved in G1 or G2/M arrest. The structure of p53 comprises an N-terminal transactivation domain, a central DNA-binding domain, an oligomerisation domain, and a C-terminal regulatory domain. There are various phosphorylation sites on p53, of which the phosphorylation at Ser15 is important for p53 activation and stabilization. p53 has been characterized to play a role in blocking the proliferative action of damaged cells and act as an anticancer agent. Phosphorylation of Ser392 in p53 has been shown to associate with the formation of human tumors. In addition, p53 has also been linked to the effects of aging and oxidative stress and an increase in p53 has been linked to deficits in LTP (Long Term Potentiation) in learning and memory. p53 is found in very low levels in normal cells, however, in a variety of transformed cell lines, it is expressed in high amounts, and believed to contribute to transformation and malignancy. Mutants of p53 that frequently occur in a number of different human cancers fail to bind the consensus DNA binding site, and cause the loss of tumor suppressor activity. Alterations of the TP53 gene occur not only as somatic mutations in human malignancies, but also as germline mutations in some cancer-prone families such as Li-Fraumeni syndrome.
仅用于科研。不用于诊断过程。未经明确授权不得转售。
篇参考文献 (0)
生物信息学
蛋白别名: Antigen NY-CO-13; Cellular tumor antigen p53; Cys 51 Stop; FLJ92943; HGNC11998; mutant tumor protein 53; OTTMUSP00000006194; p53 tumor suppressor; Phosphoprotein p53; transformation-related protein 53; tumor protein 53; Tumor suppressor p53; tumor supressor p53; Tumour Protein p53
基因别名: BCC7; LFS1; P53; TP53; TRP53
UniProt ID: (Human) P04637
Entrez Gene ID: (Human) 7157